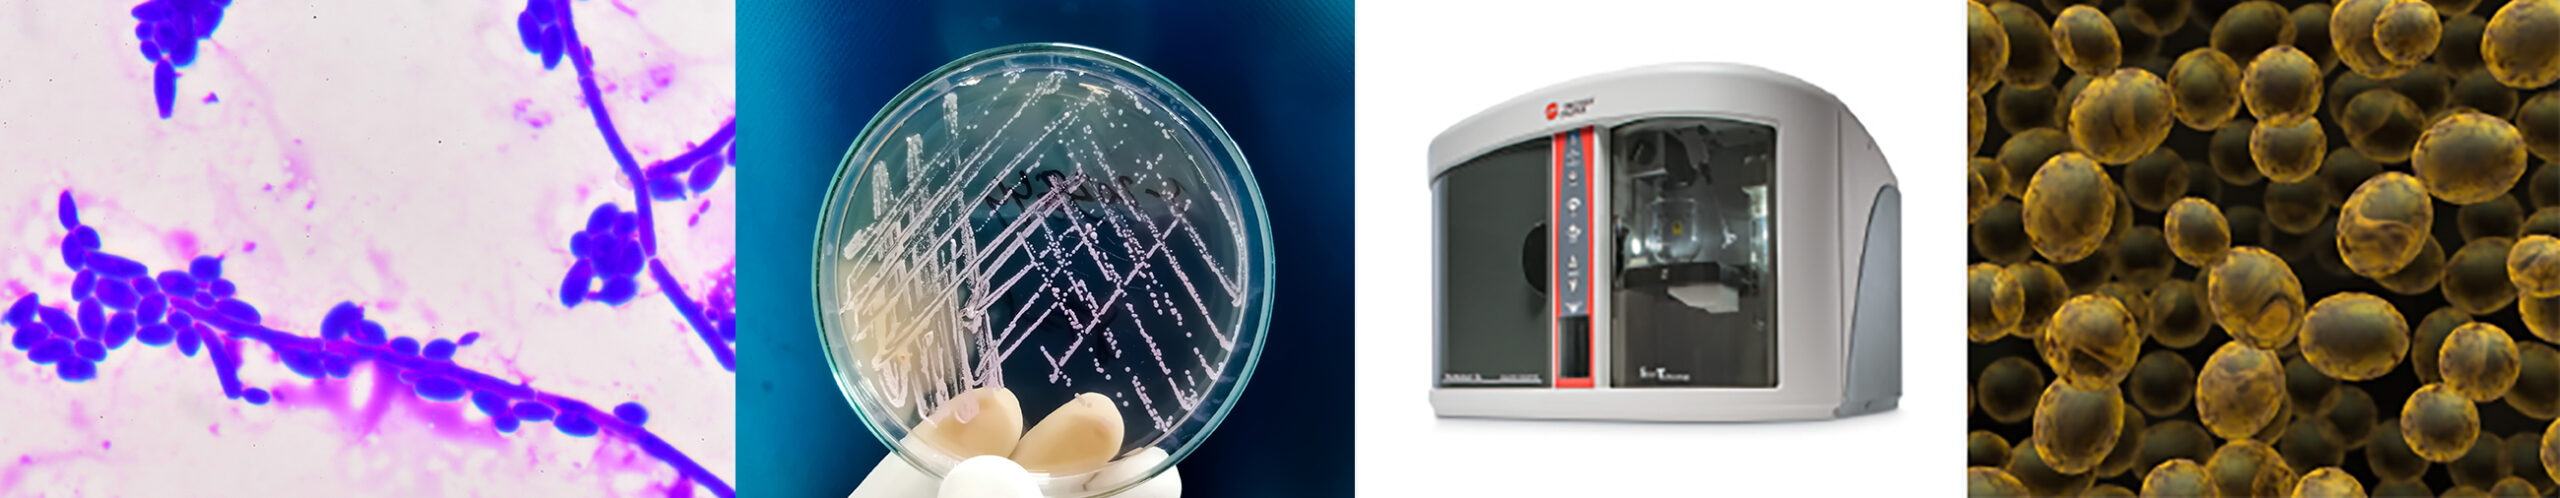

Additive Manufacturing
Industry Information
Additive Manufacturing
Why particle characterisation is important in additive manufacturing
Particle characterisation is of paramount importance in additive manufacturing (AM), commonly known as 3D printing, where precise control over material properties at the micro and nanoscale is crucial for achieving desired outcomes. Understanding the characteristics of particles in raw materials, such as powders or liquid resins, is essential for optimising the AM process and ensuring the quality and performance of the final printed products.
Understanding Particle Size
Particle size affects powder flow, surface finish and print consistency in additive manufacturing. Fine particles enhance resolution and quality but may encounter process challenges, coarse particles can lead to poor flow and uneven layer deposition.
Meritics offer a range of particle size analysers from Nanoparticle size analysers capable of analysing down to 10nm to Laser Diffraction Analysers analysing up to 3500 µm.
Analysing Powder Flow
Powder flow directly impacts the uniformity and consistency of material deposition. Proper flow minimises defects and optimises part quality. Poor powder flow can lead to irregularities compromising the structural integrity and surface finish of printed parts.
Meritics are proud to be the UK distributors of Mercury Scientifics full Powder Flow Analyser range.
Assessing the Surface Area
Surface area analysis helps understand powder characteristics, affecting powder flow, melting behavior, and part properties in additive manufacturing. It guides material selection and process optimisation for enhanced print quality.
See below the range of Surface Area Analysers Meritics offer
Case study

We wanted to test the impact of re-using the ‘waste’ metal powders from our DMLS process. Using the Mercury Scientific Revolution we were able to test, virgin powder, used powder and 50:50. The results showed us what we expected to see that the used powder didn’t flow as well and caked more than the virgin powder. From this we have been able to set standards within our production and can test the flowability using our Revolution before re-use and determine whether a batch needs to be re-processed.